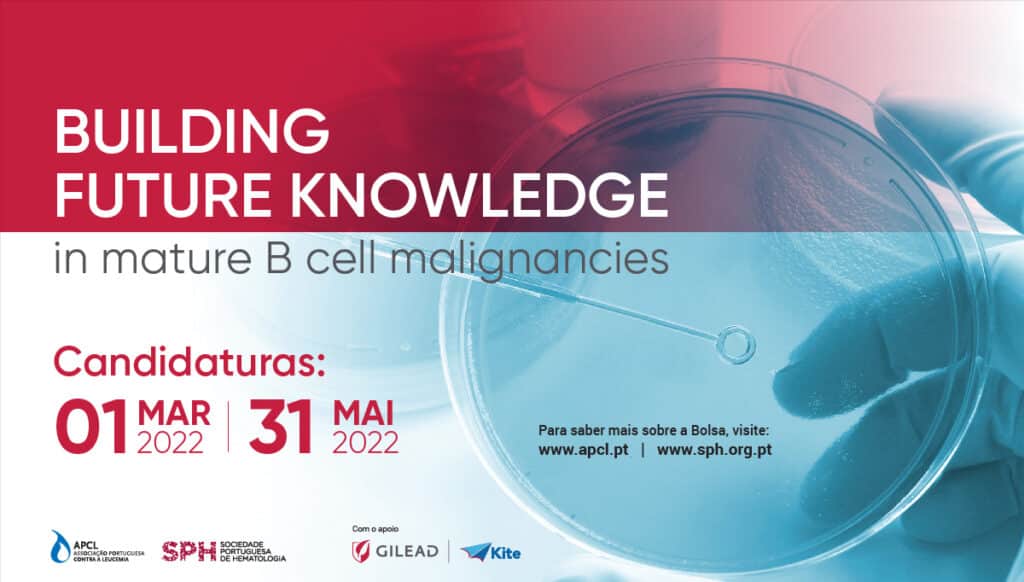

A 4.ª edição da bolsa “Building Future Knowledge in mature B cell malignacies” abriu candidaturas no dia 1 de março, com encerramento agendado para dia 31 de maio de 2022. A bolsa tem como objetivo promover a investigação científica e epidemiológica nas áreas das neoplasias de células B maduras e é uma iniciativa da Associação Portuguesa Contra a Leucemia (APCL), em parceria com a Sociedade Portuguesa de Hematologia (SPH) e conta com o apoio da biofarmacêutica Gilead Sciences. O prémio no valor de 15 mil euros será atribuído ao projeto de investigação mais promissor.
“É com grande satisfação que nos voltamos a juntar à APCL e à Gilead para estes projetos. Pela 4.ª vez, pretendemos encorajar a comunidade científica na investigação das doenças hemato-oncológicas malignas, porque acreditamos que a participação nestes projetos é uma mais-valia para o avanço da medicina”, refere João Raposo, presidente da SPH.
Todos os investigadores, nacionais ou estrangeiros, que estejam a desenvolver projetos em instituições portuguesas na área de investigação científica e/ou epidemiológica em neoplasias B de células maduras, podem candidatar-se à bolsa de investigação, até dia 31 de maio. São valorizados projetos de carácter interdisciplinar e de colaboração entre instituições, com foco no estudo das áreas de tratamento, diagnóstico, epidemiologia, qualidade de vida dos doentes e impacto a nível sociológico.
Para Manuel Abecasis, presidente da APCL, “a hemato-oncologia é das áreas oncológicas com maior taxa de sucesso de cura definitiva, para continuarmos a manter esses números é necessário continuar o estudo e investigação. Os estímulos à investigação científica em Portugal continuam a ser uma prioridade para a APCL, até porque essa é também uma forma de apoiar os nossos doentes, uma vez que é assim que se trilham os caminhos de descoberta de novos medicamentos”.
“A missão da Gilead é contribuir para um mundo com mais saúde para todos. Apoiar bolsas de investigação como esta, é um meio para atingir esse nosso objetivo. Acreditamos no valor da investigação científica desenvolvida em Portugal e temos grande expectativa relativamente aos trabalhos que serão apresentados nesta edição.”, refere Vítor Papão, Diretor Geral da Gilead Sciences Portugal.
As candidaturas à 4.ª edição da bolsa “Building Future Knowledge in mature B cell malignacies” podem ser enviadas para o email bolsas@apcl.pt até dia 31 de maio. Para mais informações pode consultar o regulamento no site da APCL.






